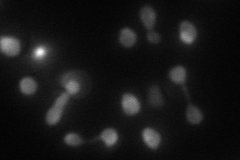
YKL021C
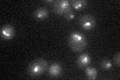
YKL021C

View description
Protein involved in an early, nucleolar step of 60S ribosomal subunit biogenesis; essential for cell growth and replication of killer M1 dsRNA virus; contains four beta-transducin repeats
Localization:
Intensity:
Fold change:
Significance:
-
C’ GFP library in SD

nucleus49.92 -
N' NOP1pr-GFP in SD

nucleolus,nuclear periphery81.2714 -
N' TEF2pr-mCherry in SD
nucleus,nucleolus39.9824 -
N' NATIVEpr-GFP in SD

below threshold13.39 -
N' TEF2pr-VC and Cyto-VN in SD

below threshold25.1916 -
C’ GFP library in SD+DTT

nucleus36.570.73No -
C’ GFP library in SD+H2O2

nucleus51.241.02No -
C’ GFP library in Starvation Media
nucleus30.210.6Yes -
C’ GFP library on the background of Pup2-DaMP

nucleus -
C’ GFP library on the background of CCT mutant

nucleus47.0350.942068No
